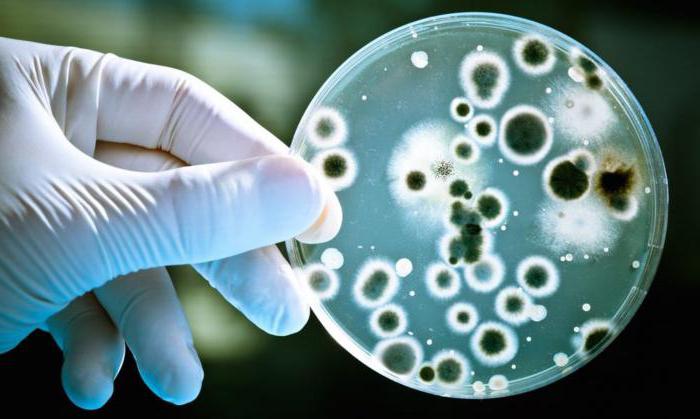

Амоксиклав – это комбинированный препарат, в состав которого входит полусинтетический пенициллин и клавулановая кислота. Данное лекарственное средство применяется для антибактериальной терапии при многих заболеваниях инфекционной этиологии.
Лекарственные формы и состав Амоксиклава
Амоксиклав производится в виде обычных и диспергируемых таблеток, в состав которых входит β-лактамный антибиотик амоксициллин (250, 500 или 875 мг амоксициллина тригидрата) и ингибитор β-лактамаз клавулановая кислота (125 мг клавуланата калия).
Средство выпускается в виде готовой суспензии и порошка для ее самостоятельного приготовления. В 5 мл суспензии присутствует 125, 250 или 400 мг полусинтетического пенициллина, а также 31,25, 62,5 или 57 мг калиевой соли клавулановой кислоты соответственно.
Жидкая форма поставляется во флаконах по 35, 50, 70 и 140 мл, а таблетированная – в блистерах по 2, 5, 6, 8 и 20 штук.
Амоксиклав является комбинированным антибиотиком, который содержит амоксициллин и клавулановую кислоту. Врачи отмечают его эффективность в лечении различных инфекций, включая заболевания дыхательных путей, мочевыводящих путей и кожи. Однако, как и любой антибиотик, Амоксиклав имеет противопоказания. К ним относятся аллергия на компоненты препарата, тяжелые нарушения функции печени и почек, а также инфекционный мононуклеоз. Специалисты подчеркивают важность соблюдения дозировки и продолжительности курса лечения, чтобы избежать развития антибиотикорезистентности. В случае необходимости замены Амоксиклава, доступны аналоги, такие как Аугментин и Флемоксин Солютаб, которые также обладают схожим действием, но могут иметь разные побочные эффекты. Врачи рекомендуют перед началом лечения проконсультироваться с медицинским специалистом для выбора наиболее подходящего препарата.

Фармакологическое действие
Амоксициллин представляет собой антибиотик, активный в отношении широкого спектра представителей болезнетворной микрофлоры. Многие бактерии синтезируют β-лактамазу, которая делает средство пенициллинового ряда неэффективным. Поэтому в состав включен ингибитор данного энзима – клавулановая кислота. Ее калиевая соль образует с разрушающим антибиотик ферментом стабильный неактивный комплекс.
Препарат равномерно распределяется в тканях и жидких средах организма. После приема per os наивысшая концентрация в плазме фиксируется спустя 60 минут. Степень биодоступности амоксициллина тригидрата составляет 90%, а клавуланата калия – около 70%.
Процесс биотрансформации ЛС протекает в печени, а неизмененное вещество и его метаболиты экскретируются преимущественно с мочой.
При каких заболеваниях помогает Амоксиклав?
Данный антибиотик эффективен при инфекционных заболеваниях, обусловленных бактериями, чувствительным к β-лактамным препаратам.
Показаниями к назначению Амоксиклава являются:
- синусит (острый или хронический);
- отит;
- фарингит;
- воспаление миндалин;
- заглоточный абсцесс;
- бронхит;
- воспаление легких;
- цистит;
- пиелонефрит;
- холецистит;
- холангит;
- инфекционные дерматиты;
- венерические заболевания (в частности – гонорея);
- инфицированные раны (в т. ч. после укусов насекомых и животных);
- гинекологические заболевания инфекционного генеза;
- артриты (с инфекционным компонентом);
- остеомиелит.
Амоксиклав — это комбинированный антибиотик, который часто назначают для лечения инфекционных заболеваний, вызванных чувствительными к нему микроорганизмами. Он содержит амоксициллин и клавулановую кислоту, что усиливает его действие и помогает преодолевать устойчивость бактерий. Многие пациенты отмечают его эффективность при лечении заболеваний дыхательных путей, мочевыводящих путей и кожи. Однако, как и любой антибиотик, Амоксиклав имеет противопоказания. Его не рекомендуют применять при аллергии на компоненты препарата, тяжелых заболеваниях печени и почек, а также во время беременности и лактации без консультации врача. Существуют и аналоги, такие как Аугментин и Флемоксин Солютаб, которые могут быть использованы в случае непереносимости Амоксиклава. Важно помнить, что самостоятельное назначение антибиотиков может привести к серьезным последствиям, поэтому всегда стоит обращаться к специалисту.

Кому противопоказан Амоксиклав?
Препарат противопоказан лицам с индивидуальной гиперсенситивностью к активным или вспомогательным ингредиентам, а также с повышенной чувствительностью к другим антибактериальным средствам пенициллинового ряда. Осторожность необходимо соблюдать при аллергии на цефалоспорины в анамнезе.
Обратите внимание
Нельзя принимать Амоксиклав, если использование амоксициллина в сочетании с клавулановой кислотой вызывало печеночную дисфункцию или застой желчи.
К числу прочих противопоказаний относятся:
- тяжелая почечная дисфункция;
- лимфолейкоз;
- псевдомембранозный колит;
- печеночная недостаточность (на фоне гепатита или алкогольного поражения);
- инфекционный мононуклеоз.
Важно
Данное антибактериальное средство в таблетированном виде не назначается детям и подросткам, не достигшим 12-летнего возраста.
Рекомендованные дозировки
Обратите внимание
Амоксициллин предназначен для курсового лечения; продолжительность курса составляет от 5 дней до 2 недель. Продолжительное бесконтрольное применение и прерывание курса могут способствовать формированию резистентности к антибиотику у патогенной микрофлоры.
В пересчете на амоксициллин при легком или среднетяжелом течении инфекционного заболевания принимают по 250 мг препарата с 8-часовыми интервалами (3 таб. в сутки).
При тяжелых бактериальных инфекциях и заболеваниях респираторной системы показан прием 500 мг каждые 8 ч. или 100 мг 2 раза в сутки.
Предельная уточная доза амоксициллина тригидрата для пациентов старше 12 лет – 6 г, а клавуланата калия – 600 мг.
Детям до 12 лет можно давать суспензию. Дозировка определяется из расчета 45 мг/кг/сут. (по амоксициллину) и 10 мг/кг/сут. (по клавулановой кислоте). Чтобы жидкую форму было проще отмерять, в комплект поставки входят пипетки или мерные ложечки на 5 мл.
Обратите внимание
Одонотогенные инфекции (периодонтит, периостит) требуют приема таблеток 250/125 мг 3 раза в сутки на протяжении 5 дней.
Для суспензий по 125 и 250 мг амоксициллина на 5 мл:
Малышам первых 3 месяцев жизни дают по 30 мг/кг препарата в сутки, разделяя дозу на 2 приема. Детям от 3 мес. назначают (в зависимости от тяжести течения инфекционного процесса) от 20 до 40 мг/кг в сутки, разделяя объем на 3 приема.
Для суспензий по 400 мг/5 мл:
Амоксиклав с высокой концентрацией антибактериального компонента дают по 25-45 мг/кг/сут. при тяжелых инфекциях, разделяя дозу на 2 приема.
Обратите внимание
Во флакон с порошком для приготовления суспензии нужно добавить кипяченой или дистиллированной воды до риски, закрыть емкость крышкой, и активно встряхивать вплоть до получения гомогенной жидкости.

Побочные эффекты
Большинство пациентов без осложнений переносит курсовую антибиотикотерапию Амоксиклавом. При индивидуальной непереносимости возможно развитие аллергических реакций в виде кожного зуда, высыпаний (крапивницы) и ангионевротического отека. В тяжелых ситуациях не исключен анафилактический шок.
В редких случаях отмечаются следующие нежелательные эффекты:
- диспепсические расстройства;
- анорексия (ухудшение или потеря аппетита);
- диарея;
- печеночная недостаточность;
- гепатит;
- холестаз (сопровождается желтушностью склер и кожных покровов);
- кандидоз (на фоне дисбактериоза);
- суперинфекции (при выработке микрофлорой устойчивости).
Передозировка
При существенном превышении возрастных разовых и (или) суточных дозировок возможны различные расстройства пищеварительной функции и нарушения водно-солевого равновесия. Не исключено также почечная дисфункция.
Важно
На фоне передозировки иногда отмечается психомоторное возбуждение, немотивированное чувство тревоги, нарушения сна и судороги.
Пострадавшему требуется очищение желудка и симптоматическая терапия. Целесообразно дать пациенту энтеросорбенты (по возрастным показаниям это могут быть активированный уголь, Смекта, Энтеросорб и т.д.). В тяжелых ситуациях может понадобиться госпитализация пострадавшего в профильное отделение стационара и проведение аппаратного очищения крови – гемодиализа.
Взаимодействие Амоксиклава с прочими ЛС
Плазменная концентрация антибиотика возрастает на фоне приема Пробенецида.
Амоксиклав увеличивает общую токсичность Метотрексата вследствие замедления экскреции последнего.
При сочетании с Аллопуринолом возрастает риск появления экзантемы (кожных высыпаний).
Эффективность амоксициллина может снижаться при параллельном приеме с антибиотиками-макролидами, средствами тетрациклинового ряда и сульфаниламидами.
Комбинированный антибактериальный препарат способен уменьшать эффективность противозачаточных таблеток, поскольку нарушает их абсорбцию.
Выявлен антагонизм Амоксиклава и Рифампицина (терапевтический эффект взаимно ослабляется).
Параллельное использование с непрямыми антикоагулянтами приводит к увеличению протромбинового времени, что повышает риск кровотечений различной локализации.
Амоксиклав при беременности и грудного вскармливания ребенка
Амоксициллин свободно проникает через гемато-плацентарный барьер, но этот антибиотик не обладает мутагенными, тератогенными или эмбриотоксическими свойствами. Беременным женщинам его можно принимать только по назначению лечащего врача. При необходимости проведения антибиотикотерапии во время лактации может ставиться вопрос о временном переводе грудничка на искусственные молочные смеси, хотя в грудное молоко попадает только очень малое количество антибиотика.
Дополнительно
Чтобы уменьшить вероятность диспепсических расстройств, целесообразно пить Амоксиклав сразу после приема пищи.
Правила хранения и отпуска из аптек
Для приобретения Амоксиклава рецепт врача не потребуется.
Хранить лекарственное средство следует в экранированном от солнечных лучей месте, при температуре, не превышающей +25°C.
Срок годности для суспензии и таблеток составляет 2 года с даты выпуска (отмечена на фабричной таре).
Беречь от детей!
Аналоги Амоксиклава
К числу препаратов-аналогов по действующему веществу и механизму действия относятся:
- Панклав;
- Аугментин;
- Сумамед;
- Оксамп;
- Ранклав;
- Экоклав;
- Арлет;
- Рапиклав.
Плисов Владимир, врач, медицинский обозреватель
Вопрос-ответ
Кому противопоказан Амоксиклав?
С осторожностью назначать препарат лицам с псевдомембранозным колитом в анамнезе, болезнями желудочно-кишечного тракта, нарушением функции печени, почечной недостаточностью в тяжелой форме, во время беременности и грудного вскармливания, при совместном использовании с антикоагулянтами.
Какая побочка от амоксиклава?
Побочные действия Аллергические реакции: эритематозная сыпь, зуд, крапивница, редко – многоформная экссудативная эритема, ангионевротический отек, анафилактический шок, аллергический васкулит, в единичных случаях – эксфолиативный дерматит, синдром Стивенса-Джонсона, острый генерализованный экзантематозный пустулез.
Каковы противопоказания к применению ко-амоксиклава?
Ко-Амоксиклав противопоказан пациентам с гиперчувствительностью к пенициллину в анамнезе, а также пациентам с чувствительностью к амоксициллину и холестатической желтухой или нарушением функции печени, связанными с инъекциями калия .
Советы
СОВЕТ №1
Перед началом приема Амоксиклава обязательно проконсультируйтесь с врачом. Самолечение может привести к нежелательным последствиям и ухудшению состояния здоровья.
СОВЕТ №2
Обратите внимание на противопоказания и возможные побочные эффекты. Если у вас есть аллергия на пенициллины или другие компоненты препарата, обязательно сообщите об этом врачу.
СОВЕТ №3
Следуйте рекомендованной дозировке и схеме приема, указанной в инструкции или назначенной врачом. Не прекращайте курс лечения преждевременно, даже если симптомы заболевания исчезли.
СОВЕТ №4
Если вы принимаете другие лекарства, обязательно сообщите об этом врачу, чтобы избежать возможных взаимодействий и осложнений.